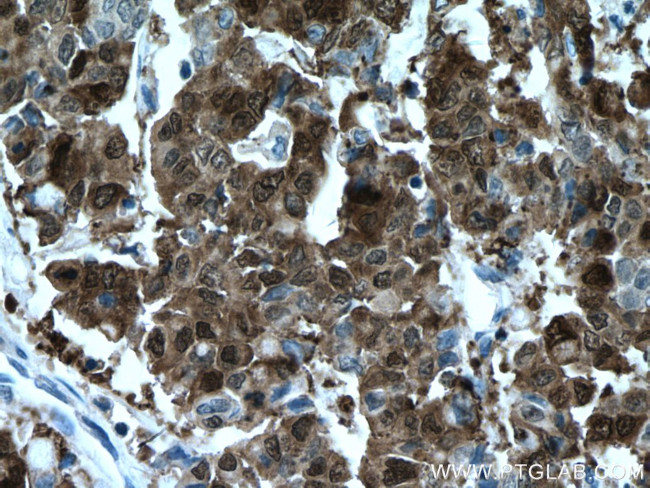
Galectin-4 Antibody in Immunohistochemistry (Paraffin) (IHC (P))

Search
Proteintech
Galectin-4 Monoclonal Antibody (3C2G3)
{{$productOrderCtrl.translations['antibody.pdp.commerceCard.promotion.promotions']}}
{{$productOrderCtrl.translations['antibody.pdp.commerceCard.promotion.viewpromo']}}
{{$productOrderCtrl.translations['antibody.pdp.commerceCard.promotion.promocode']}}: {{promo.promoCode}} {{promo.promoTitle}} {{promo.promoDescription}}. {{$productOrderCtrl.translations['antibody.pdp.commerceCard.promotion.learnmore']}}
产品信息
66686-1-IG
种属反应
宿主/亚型
分类
类型
克隆号
抗原
偶联物
形式
浓度
规格
纯化类型
保存液
内含物
保存条件
运输条件
产品详细信息
Immunogen sequence: MAYVPAPGY QPTYNPTLPY YQPIPGGLNV GMSVYIQGVA SEHMKRFFVN FVVGQDPGSD VAFHFNPRFD GWDKVVFNTL QGGKWGSEER KRSMPFKKGA AFELVFIVLA EHYKVVVNGN PFYEYGHRLP LQMVTHLQVD GDLQLQSINF IGGQPLRPQG PPMMPPYPGP GHCHQQLNSL PTMEGPPTFN PPVPYFGRLQ GGLTARRTII IKGYVPPTGK SFAINFKVGS SGDIALHINP RMGNGTVVRN SLLNGSWGSE EKKITHNPFG PGQFFDLSIR CGLDRFKVYA NGQHLFDFAH RLSAFQRVDT LEIQGDVTLS YVQI (1-323 aa encoded by BC034750)
靶标信息
The galectins are a family of beta-galactoside-binding proteins implicated in modulating cell-cell and cell-matrix interactions. The expression of this gene is restricted to small intestine, colon, and rectum, and it is underexpressed in colorectal cancer. Galectin 4 binds lactose and a related range of sugars. May be involved in the assembly of adherens junctions.
仅用于科研。不用于诊断过程。未经明确授权不得转售。
篇参考文献 (0)
生物信息学
蛋白别名: Antigen NY-CO-27; Gal-4; Galectin-4; L-36 lactose-binding protein; L36LBP; Lactose-binding lectin 4; lectin, galactoside-binding, soluble, 4; LGALS4; unnamed protein product
基因别名: GAL4; L36LBP; LGALS4
UniProt ID: (Human) P56470
Entrez Gene ID: (Human) 3960